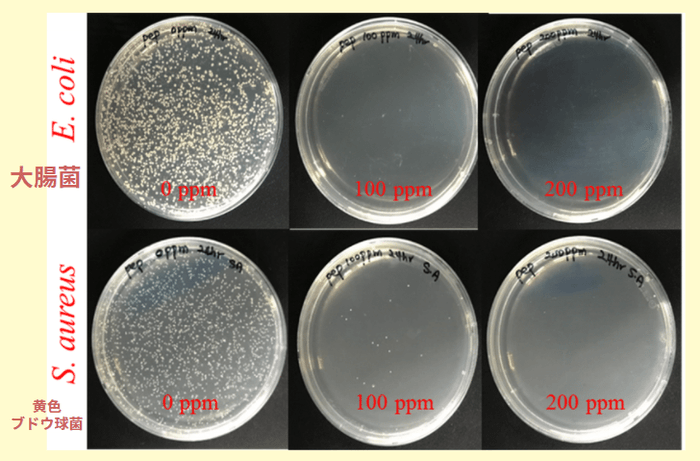
大腸菌と黄色ブドウ球菌とコロイダルシルバーをシャーレに入れた図

1/26~28 オンライン展示会出展 英国オーガニック店でも取り扱われる銀の天然抗菌成分で 家族の肌悩みに対応できる「コロイダルシルバー」
ライラインターナショナル Ltd(代表:辰岡 美智子)は、2022年1月26~28日にオンライン展示会「ヘルスケアビジネス EXPO ONLINE」に出展し、「天然の抗生物質」と呼ばれる銀の抗菌成分配合の「コロイダルシルバー」シリーズを展示いたします。日本ではまだまだ無名な「コロイダルシルバー」という成分の特徴や、どのような事に使えるのかという用途の説明をしていきたいと思います。銀には確認されているだけで650種類の菌類を死滅させる効果があります。

~ イベント概要 ~
◆ 名称:ヘルスケアビジネス EXPO ONLINE
◆ 会場:ヘルスケアビジネス EXPO ONLINE | DMMオンライン展示会
◆ 日時:2022年1月26~28日(水~金曜日)10時~16時
◆ 内容:天然抗菌成分コロイダルシルバーのご紹介
コロナ禍でマスク着用の機会が増え、肌荒れやニキビ、耳の後ろの痛みに悩む方が多くいらっしゃいます。アンケートによると約23.8%の方が「紐による耳痛」、20%が「肌荒れ・吹き出物」などのトラブルを感じていることが分かりました。(養命酒製造株式会社調べ 全国の20~69歳男女1,000名より回答)
そこで、薬や添加物が入っていないもので、家族みんなで使える「コロイダルシルバー」を紹介したいと思いました。コロイダルシルバーは文字通り銀配合で、古代から「天然の抗菌・抗真菌」の目的で、キズや湿疹、肌荒れ、ニキビにも広く使われてきました。天然成分で、月齢10か月以上のお子様にも安心してお使いいただけます。マスクによるものだけでなく、普段から敏感肌の方やアレルギー肌のお客様にもよいお声をいただいており、当社によるアンケートでは、9割以上の方が「知人・家族にも勧めたい」というお声をいただいています。
代表の辰岡もコロナの流行初期の頃、マスクの摩擦で肌がヒリヒリしたり、ニキビに悩まされたことがありました。また、娘がマスクによりかぶれを起こしたこともあります。その時に、持っていて重宝したのがこのコロイダルシルバーでした。天然成分で、症状によって複数アイテムが必要な訳でなく、一本で対応できました。
当社の取り扱うNGSの商品は、イギリスのWHOLE FOODSやハロッズにも卸販売をしており、イギリスNo.1のコロイダルシルバーメーカーです。当社は日本における独占販売権をいただいています。
今回の展示会を通して、肌トラブルに悩む方々にお勧めできる天然の成分を好まれる事業様へ、コロイダルシルバーの抗菌・消炎の効果や使い方をお伝えしていきたいと思っております。
会社概要
商号 : ライラインターナショナル Ltd
代表者 : 辰岡 美智子
所在地 : Flat2, 4 Grand Junction Place、London UK UB8 2SU
設立 : 2021年7月
事業内容: 美容・健康関係商品の販売、美容と健康に関するアドバイス
URL : https://lyrainternational.stores.jp/